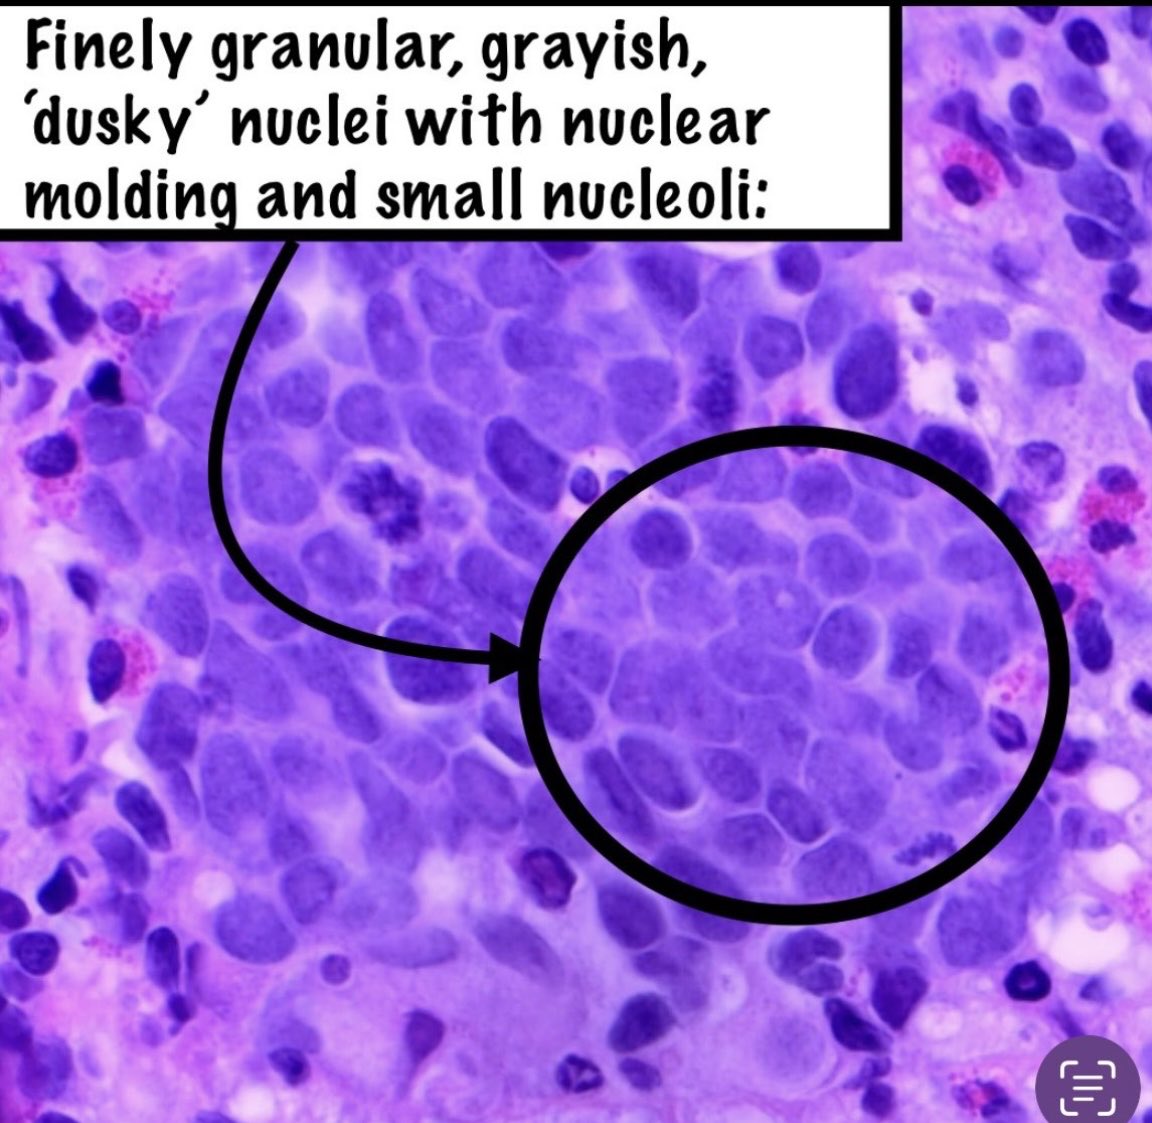
Brown Pathology and Laboratory Medicine tweet media
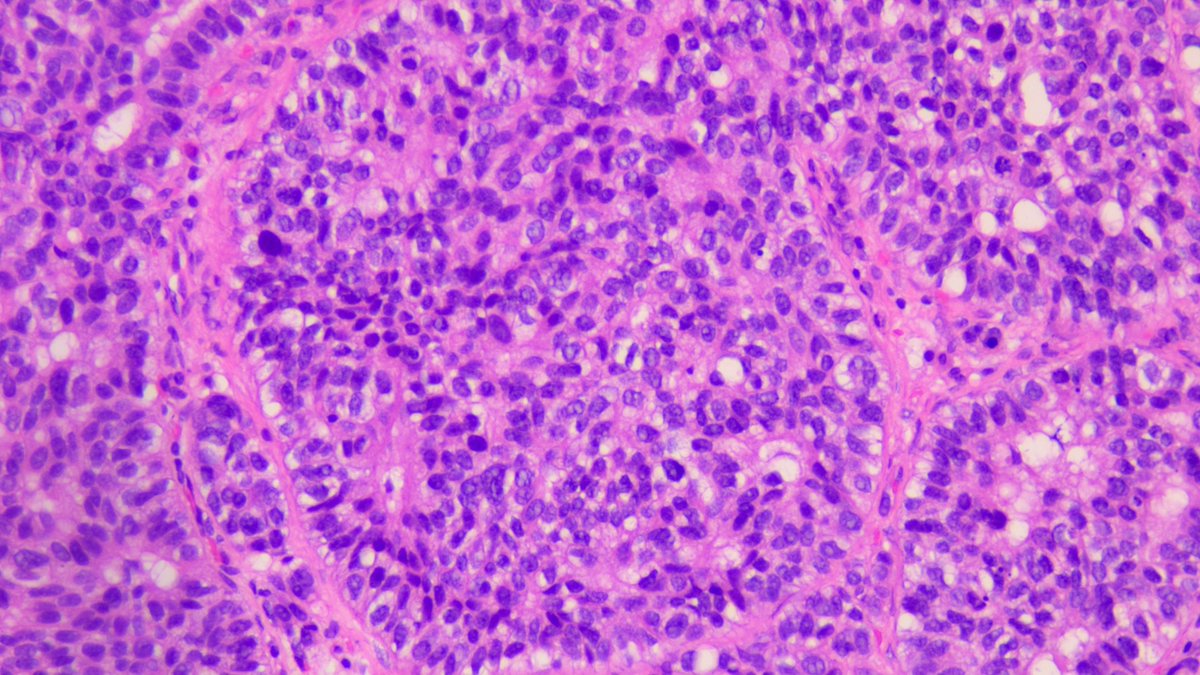
Kenny De Gracia T. tweet media

Sabitlenmiş Tweet
TheBatoolMD
782 posts

TheBatoolMD
@TheBatoolMD
PGY-3 & Chief @Umass @baystate_health #Pathologist 🔬 #Dermpath • @pathologists RF Executive Committee🦇• #Cats, #Crafts, & #Tea🫖(Tweets & cat are mine💕)
Jeddah - Massachusetts Katılım Şubat 2022
1.6K Takip Edilen1.5K Takipçiler

#GIPath #Surgpath #Pathresidents
#Pathrwitter
70 year old man with a small bowel biopsy. Take a look, cast a vote, and read for some discussion slides.


English

@BrownPathology @DrGeeONE WOOOOOOAH.
very interesting!
Thank you for sharing!
English
TheBatoolMD retweetledi
TheBatoolMD retweetledi

We want YOU to join the @MatchToPath team!
Join the growing community of pathologists helping build an internationally recognized, free platform for mentorship, advice, and webinars on applying to pathology.
Deadline Match 3oth: forms.gle/cqQmVorCzFfPyb…
#MatchToPath #Pathology

English

I created a Hematopathology High-Yield Board Review Series.
Here is part 1!
youtu.be/r-py4KxVVKo
#Pathology #Boardreview #Hematology #Hematopathology #Pathresidents

YouTube

English

@TheBatoolMD @SomaRoyChak @HistPathSoc @TheUSCAP @aubry_mc Congratulations Batool! Proud of you 👏🏻👏🏻👏🏻
English

Honored & excited to receive this recognition from the @HistPathSoc !
Grateful for the opportunity to share this work and for the mentorship & support behind it 💕
Huge motivation to keep exploring the fascinating history behind what we diagnose everyday.
@TheUSCAP
@aubry_mc
History of Pathology Society@HistPathSoc
Congratulations to our 2026 Azar Award winner Dr AlBatool AlMahdy, resident at UMass Chan Medical School, for best abstract by a trainee “From Sophie Spitz to Molecular Melanocytoma: A Historical Journey in Spitzoid Pathology”. Looking forward to her presentation at USCAP 2026.
English
TheBatoolMD retweetledi
TheBatoolMD retweetledi

#GIPath #Pathresidents #surgpath #pathX
Patterns in GI pathology 101: Hey pathologists! Anyone want to look at some pictures of ischemic colitis? How do we recognize it, and how do we report it?
This slide shows ischemic colitis juxtaposed with normal colon. See thread below


English
TheBatoolMD retweetledi

In prostate adenocarcinoma...does anyone know what those basophilic cytoplasm cells are? Do you suggest any IHC? #pathology #pathologic #uropath #uropathology #prostate @SEAP_IAP @IntSocUropath @AbhijitSurgPath @




English

If you haven’t booked for the @TheUSCAP yet, then do that >>> but come one day earlier to attend the @Pathologists CAP Spring Residents Forum Meeting #SPRF26 !
Here’s your link to register:
events.cap.org/event/SPRF26/h…
See you there!

English
TheBatoolMD retweetledi

I almost made a BIG MISDIAGNOSIS here!
80 F leg skin nodule.
Dot-like + panCK & chromogranin
Negative: CK20 synapto TTF-1 CD45
WSI:kikoxp.com/posts/21603
More IHC🤯 kikoxp.com/posts/21605
Answer✅youtu.be/coeItfvYI6w?si…
#pathology #pathTwitter #dermpath

YouTube




English

@NebbacheHafsa @AranzaPinedo @Pathologists @CAPFndn Can’t waiiiittt for our third CAP together 💕 🔥 @Pathologists
English
TheBatoolMD retweetledi

Time to change my luggage tag 😍
The real challenge now? Finding yellow outfits for #CAP26 in Las Vegas 💛
Back to Vegas next year! woot woot!! 🎉🎰
#CAP26 #PathResident #Pathology #CAP @AranzaPinedo @TheBatoolMD @Pathologists @CAPFndn #PathTwitter #PathX #WomenInMedicine #orlandoflorida #Vegas @WynnVegasHotel


English

@NebbacheHafsa @AranzaPinedo @Pathologists @CAPFndn The real Barbie @NebbacheHafsa does it right💕!!! ✨
I just show up without matching 🤣
English

@doctorarepitie1 Very interesting..
Following for the answer… 🧐
English

#ChatGPT knows me too well, I am afraid… 😅
Accurate!
#Pathology #PathX #MedTwitter #PathTwitter #laboratory #BreastPath #Cytopathology #PathResident #PathResidents


English

Epithelioid features can be seen in a variety of lesions- let's review:
What is your interpretation?
A. Epithelioid sarcoma
B. Epithelioid histiocytoma
C. Epithelioid angiosarcoma
D. Epithelioid hemangioendothelioma
#PathPearls #PathQuiz


English

@MeredithKHerman @Histopatolomon @UMichPath @DrCycloPath @DrBuiPathology Loooove the effort you put into this Meredith! AMAZING tweetorial 💕
English
TheBatoolMD retweetledi